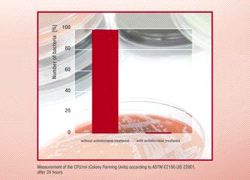

Consumables
Bacteria-free surfaces
Friday 10. October 2008 - BASFs new Luran S BX 13042 kills bacteria First antimicrobial BASF plastic
BASF is now offering a plastic that has the property of killing microbes. This material belongs to the specialties found in the styrene plastic product line. It goes by the name Luran S BX 13042 and is currently the only ASA (acrylonitrile-styrene-acrylate copolymer) with an antimicrobial effect. The product will be presented at the FAKUMA 2008 in October in Friedrichshafen, Germany. Sample amounts are already available in the color white.
The antimicrobial material contains silver compounds that are incorporated into the plastic in order to impart its surface with a germicidal effect. Interesting areas of application for this material are not only hand dryers, soap dispensers or entire sanitary units in public washroom facilities, but also other products that come into contact with bacteria and other microorganisms and that need to be sterile such as, for instance, hospital beds, medical treatment chairs or computer keyboards in public offices. The combination with the classic ASA properties such as weathering resistance, high thermal-ageing stability, good chemical resistance and outstanding surface quality yields a new material with an extraordinary property profile.
